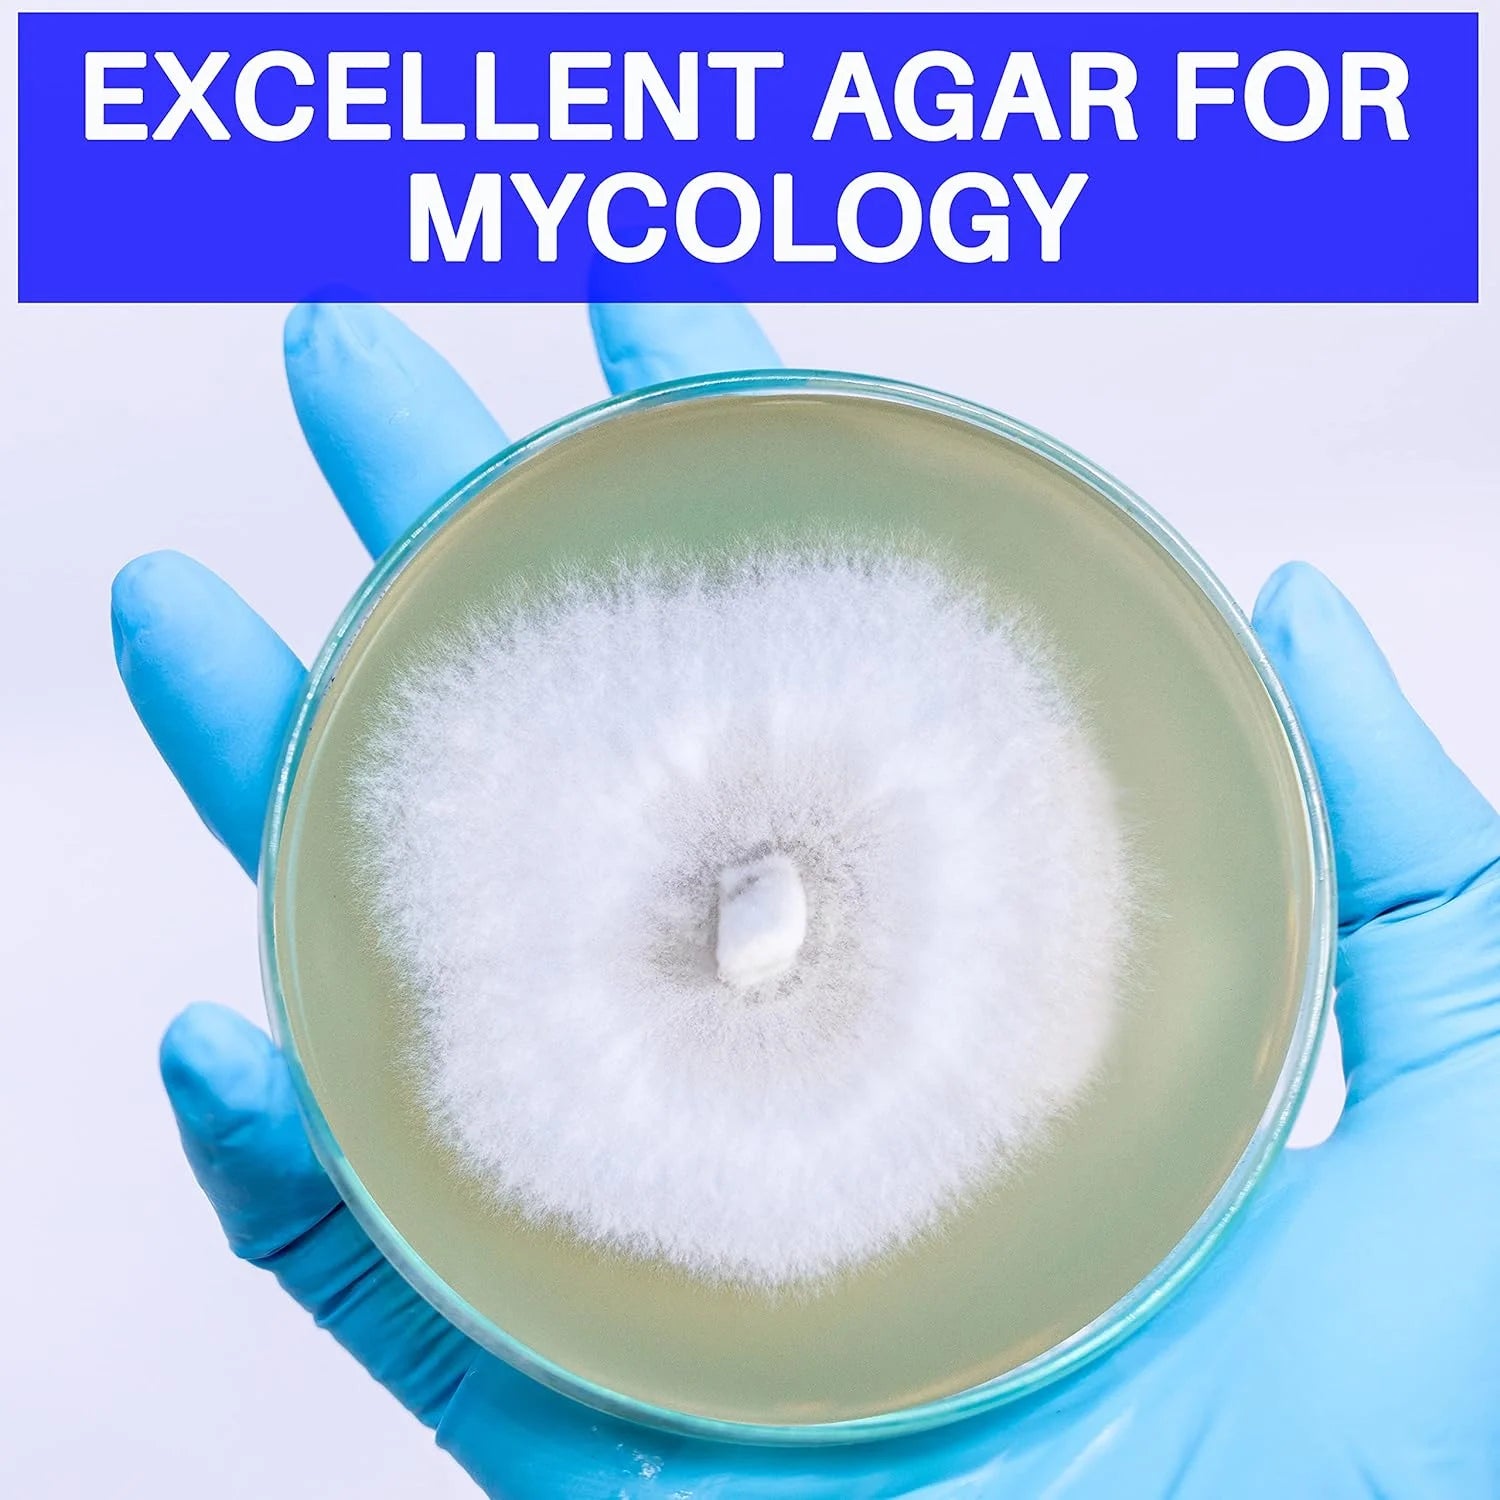

1
/
of
7
CultivationCult
Malt Extract Agar Powder 100G by , Can Make over 100 Agar Petri Dishes, for Mold & Fungus, Ideal for Mushrooms & Science Projects
Malt Extract Agar Powder 100G by , Can Make over 100 Agar Petri Dishes, for Mold & Fungus, Ideal for Mushrooms & Science Projects
Regular price
$44.83 USD
Regular price
$0.00 USD
Sale price
$44.83 USD
Unit price
/
per
Couldn't load pickup availability
Malt Extract Agar Powder 100g by Evviva Sciences, Can Make Over 100 Agar Petri Dishes, for Mold & Fungus, Ideal for Mushrooms & Science Projects
- A SOLID SELECTION WITH VALUE - Evviva Sciences Malt Extract Agar Powder is an ideal option if you are making your own agar. Pouring your own agar is both fun and economical. You will be able to pour 100 Petri dishes or more with our agar powder.
-
- ENHANCE YOUR RESEARCH USING INDUSTRY STANDARD AGAR: At Evviva Sciences, we have a fully equipped laboratory and we manufacture industry standard agar powder. Our agar is packed with nutrients and forms a solid surface that is suitable for microbiology.
- FOR MYCOLOGY AND MUSHROOM CULTURE: Our Malt Extract Agar powder is ideal for use in a variety of agar-based products, including agar plates, agar slants, and other culture studies and experiments.
-
- FUN & EASY TO USE: Crafting agar plates at home is a hassle-free and practical way to save money. It's also an enjoyable activity that you can easily perform. Our malt extract agar powder allows you to produce over 100 plates.
- PROFESSIONAL CONSULTATION AVAILABLE: At Evviva Sciences, we have a team of PhD scientists and we will help you with all parts of your culture experiments. We always respond efficiently to all messages. If you have technical questions about your mycology experiments, we are here to help.
Share